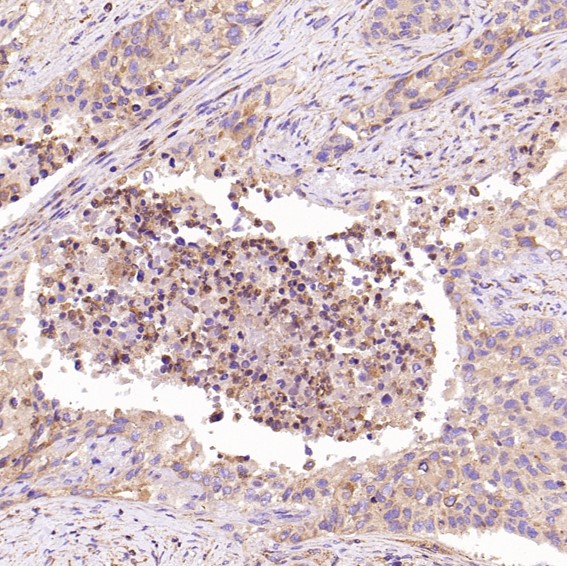

单克隆抗体
CEBP alpha Antibody (CY5723)
UniProt:P49715
Application:WB,IP,FC
Reactivity:Human,Mouse,Rat
Source:Rabbit mAb
CEBP alpha Antibody (CY5723)
UniProt:P49715
Application:WB,IP,FC
Reactivity:Human,Mouse,Rat
Source:Rabbit mAb
http://www.abways.cn/showproduct.asp?cid=CY5723
Ret Antibody (CY5724)
UniProt:P07949
Application:WB,IHC,ICC/IF,IP,FC
Reactivity:Human,Mouse,Rat
Source:Rabbit mAb
Ret Antibody (CY5724)
UniProt:P07949
Application:WB,IHC,ICC/IF,IP,FC
Reactivity:Human,Mouse,Rat
Source:Rabbit mAb
http://www.abways.cn/showproduct.asp?cid=CY5724
TOP1 Antibody (CY5725)
References (1)
UniProt:P11387
Application:WB,IHC,ICC/IF,FC
Reactivity:Human,Mouse
Source:Rabbit mAb
TOP1 Antibody (CY5725)
UniProt:P11387
Application:WB,IHC,ICC/IF,FC
Reactivity:Human,Mouse
Source:Rabbit mAb
References(1)
http://www.abways.cn/showproduct.asp?cid=CY5725
JAG1 Antibody (CY5726)
UniProt:P78504
Application:WB,IHC
Reactivity:Human
Source:Rabbit mAb
http://www.abways.cn/showproduct.asp?cid=CY5726
ADIPOR1 Antibody (CY5727)
UniProt:Q96A54
Application:WB,IHC,ICC/IF,FC
Reactivity:Human,Mouse,Rat
Source:Rabbit mAb
ADIPOR1 Antibody (CY5727)
UniProt:Q96A54
Application:WB,IHC,ICC/IF,FC
Reactivity:Human,Mouse,Rat
Source:Rabbit mAb
http://www.abways.cn/showproduct.asp?cid=CY5727

销售咨询
一键电话